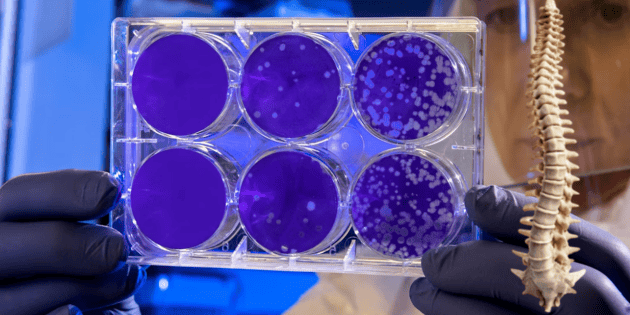

Renseignez-vous sur le nouveau traitement qu’ils développent pour les lésions de la moelle épinière.
Une étude récente a révélé qu'un nouveau procédé est en cours de développement, qui combine l'impression 3D, les cellules souches et les tissus cultivés en laboratoire , et qui pourrait constituer une innovation majeure pour la récupération des lésions de la moelle épinière.
Ce procédé crée des cellules souches par impression 3D sur des supports contenant des canaux microscopiques, qui guident la croissance de nouvelles cellules autour de la lésion médullaire. Voici son fonctionnement.
Croissance cellulaire grâce à l'impression 3DGuebum Han, l'auteur principal de cette recherche, a expliqué dans un communiqué : « Nous avons utilisé les canaux imprimés en 3D de l'échafaudage pour diriger la croissance des cellules souches, ce qui assure que les nouvelles fibres nerveuses se développent de la manière souhaitée ".
« Cette méthode crée un système de relais qui, lorsqu'il est placé dans la moelle épinière, contourne la zone endommagée », a déclaré Han, ancien chercheur postdoctoral à l'Université du Minnesota et actuellement ingénieur en mécanique chez Intel Corp.
Lire : Ils mettent en garde contre la fin de l'humanité aux mains de l'IAÀ ce jour, il n'existe aucun traitement permettant d'inverser les dommages et la paralysie causés par les lésions de la moelle épinière, une affection qui touche des milliers de personnes dans le monde. Le principal problème réside dans l' incapacité des cellules nerveuses à se régénérer spontanément à l'endroit de la lésion, ce qui rend les lésions permanentes.
Dans cette étude, les chercheurs ont transplanté des échafaudages imprimés en 3D chez des rats dont la moelle épinière était complètement sectionnée. Ces cellules sont devenues avec succès des neurones et ont fait pousser des fibres nerveuses dans les deux sens, le long de la colonne vertébrale, dans le but de former de nouvelles connexions avec la moelle épinière blessée des rats.
Les résultats ont montré qu’au final, les nouvelles cellules nerveuses s’intégraient parfaitement dans la moelle épinière , rétablissant ainsi complètement le mouvement et la fonction.
L’équipe de recherche espère continuer à tester cette combinaison de technologies, et préparez-le pour de futurs tests sur l’homme.
Lire : Instagram lance une nouvelle fonctionnalité avec sa récente mise à jour* * * Restez au courant des actualités, rejoignez notre chaîne WhatsApp * * https://www.whatsapp.com/channel/0029VaAf9Pu9hXF1EJ561i03
AU
informador